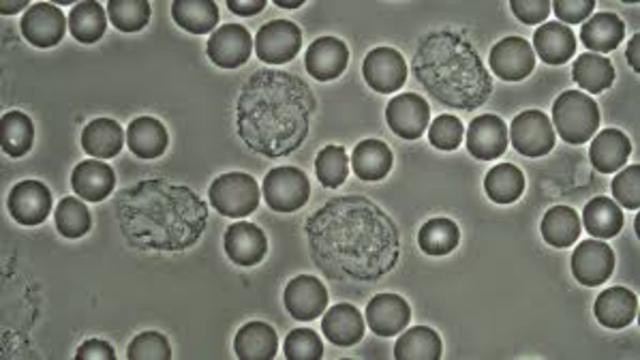
¿Lo pequeño e invisible se puede ver?

Historia de la microscopía. Fuente: Microscopes en Nobel Prize.org; History of Microscopes Zeiss.com; IBM. Scanning Tunneling Microscope.
-
Gerd Binnig y Heinrich Rohrer desarrollan un sistema para conocer la superficie de los objetos. Con esto se puedo manipular los átomos para construir estructuras como las que hoy se usan para construir circuitos. Con ello lograron ganar premio nobel en física en 1986.
-
Ernst Ruska desarrolla microscopía electrónica, donde reemplaza la luz por electrones, lo que aumenta el límite de resolución.
-
Firts Zernike desarrolló un sistema que permitía observar el cambio en la fase de la luz al pasar a través de un objeto. Esto permitió observar células transparentes, lo que mejoró la observación de los tejidos y células vivas. Este descubrimiento lo llevo a obtener el premio nobel en Física en 1932.
-
Richard Zsigmondy desarrolla un microscopio que utiliza la luz dispersada en vez de la reflejada. Esto permitió observar objetos bajo la longitud de onda. Estas observaciones aceptaron el inicio de la microscopía de fluorescencia y le valieron el premio nobel de la física en 1925.
-
Ernest Abbe, desarrolla la primera formalización matemática que describe la máxima resolución de un microscopio óptico. Establece una relación entre la longitud de Onda y la refracción.
-
Lister, un productor de vinos desarrolla lentes que permiten corregir la aberración esférica, junto con aumentar la distancia de la muestra sin producir una deformación de la imagen. Su hijo Joseph Lister mas tarde utilizó esta herramienta en sus investigaciones sobre la asepsia y los tratamientos quirúrgicos.
-
Debido al gran uso del microscopio, la tecnología invierte en mejorar las lentes para corregir los bordes coloreados cuando se observa un objeto a través de una lente, o también llamadas aberraciones cromáticas.
-
Anton Van Leeuwenhoek utiliza un microscopio con un solo lente para mirar seres vivos pequeños y sangre. El Observa por primera vez bacterias y protozoos en movimiento.
-
Robert Hooke presenta las primeras imágenes al microscopio. Descubrió las células a partir de la observación de una lámina de corcho.
-
Hans Thomas Janssen desarrolla el primer microscopio compuesto, al poner dos lentes en un tubo.
-
Construcción de los primeros lentes cóncavos y convexos.
Want to make a timeline like this?
Use Timetoast to turn dates, events, milestones, and phases into a clear visual timeline you can build and share. Timetoast is a timeline maker for work, school, research, and stories.